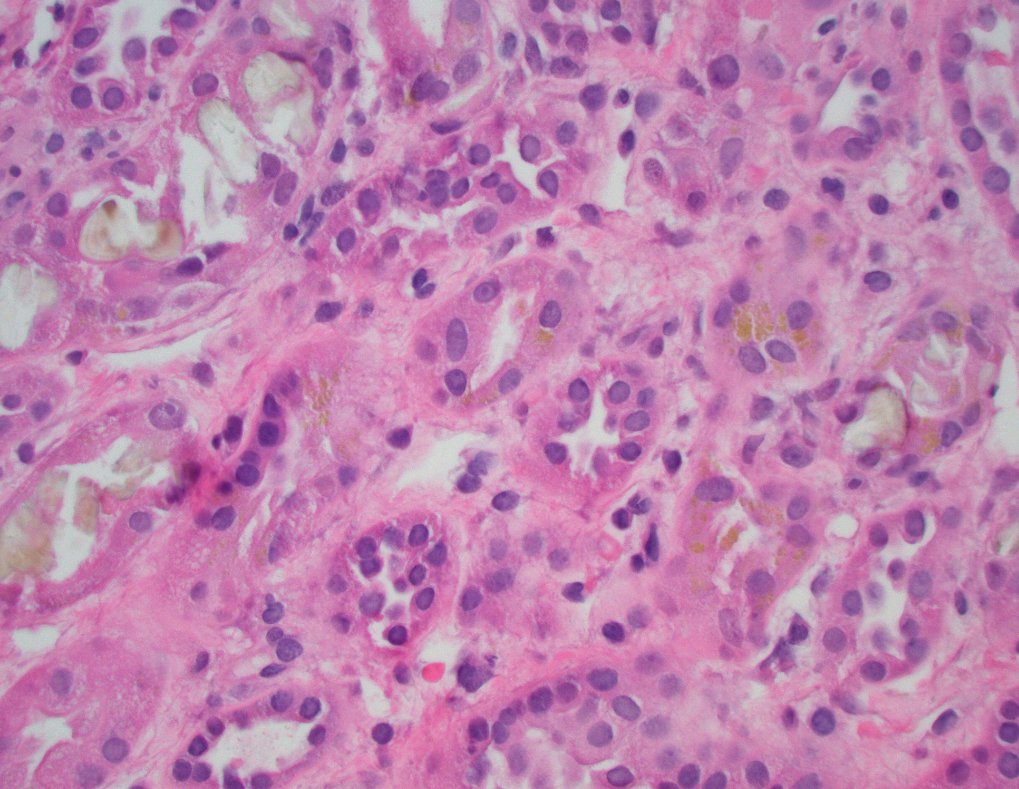
Jonathan Zuckerman MD PhD tweet media

@elonmusk I think you mean GLP-1 receptor agonists, not GLP inhibitors.
English
Kelly Smith
40 posts



Luigi Mangione's manifesto includes a superficially damning claim. However, it's wrong. Want to understand why the US spends so much on healthcare to get such poor results? Read this thread to see the greatest (and most unknown) analysis of US healthcare ever done.